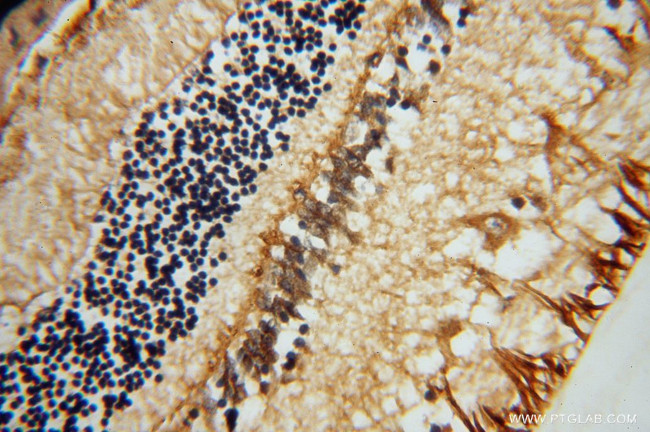
RLBP1 Antibody in Immunohistochemistry (Paraffin) (IHC (P))

Search
Proteintech
RLBP1 Polyclonal Antibody
{{$productOrderCtrl.translations['antibody.pdp.commerceCard.promotion.promotions']}}
{{$productOrderCtrl.translations['antibody.pdp.commerceCard.promotion.viewpromo']}}
{{$productOrderCtrl.translations['antibody.pdp.commerceCard.promotion.promocode']}}: {{promo.promoCode}} {{promo.promoTitle}} {{promo.promoDescription}}. {{$productOrderCtrl.translations['antibody.pdp.commerceCard.promotion.learnmore']}}
产品信息
15356-1-AP
种属反应
已发表种属
宿主/亚型
分类
类型
抗原
偶联物
形式
浓度
规格
纯化类型
保存液
内含物
保存条件
运输条件
产品详细信息
Immunogen sequence: MSEGVGTFR MVPEEEQELR AQLEQLTTKD HGPVFGPCSQ LPRHTLQKAK DELNEREETR EEAVRELQEM VQAQAASGEE LAVAVAERVQ EKDSGFFLRF IRARKFNVGR AYELLRGYVN FRLQYPELFD SLSPEAVRCT IEAGYPGVLS SRDKYGRVVM LFNIENWQSQ EITFDEILQA YCFILEKLLE NEETQINGFC IIENFKGFTM QQAASLRTSD LRKMVDMLQD SFPARFKAIH FIHQPWYFTT TYNVVKPFLK SKLLERVFVH GDDLSGFYQE IDENILPSDF GGTLPKYDGK AVAEQLFGPQ AQAENTAF (1-317 aa encoded by BC004199)
靶标信息
Cellular retinaldehyde-binding protein (CRALBP) plays an important role in the regeneration of 11-cis-retinal for use in rod visual pigments such as opsin and rhodopsin. Once 11-cis-retinal is photoisomerized in the rod outer segment, it is converted to all-trans-retinal and further modified into all-trans-retinol. All-trans-retinol then diffuses into the retinal pigment epithelium (RPE) to be converted back to 11-cis-retinol and further oxidized into 11-cis-retinal (both by CRALBP). Genetic mutations involving CRALBP's lack of function have been linked to visual disease such as bothnia dystrophy, retinitis punctata albescens, retina pigmentosa, and Newfoundland rod-cone dystrophy. The presence of CRALBP serves as a marker for RPE and Muller glial cells of the retina.
仅用于科研。不用于诊断过程。未经明确授权不得转售。
生物信息学
蛋白别名: Cellular retinaldehyde-binding protein; cellular retinaldehyde-binding protein-1; Retinaldehyde-binding protein 1; retinaldehyde-binding protein precursor; unnamed protein product
基因别名: 3110056M11Rik; CRALBP; RLBP1
UniProt ID: (Human) P12271, (Mouse) Q9Z275
Entrez Gene ID: (Human) 6017, (Mouse) 19771, (Rat) 293049